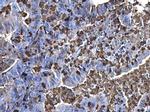
S100A9 Antibody in Immunohistochemistry (Paraffin) (IHC (P))

Search
Invitrogen
S100A9 Polyclonal Antibody
{{$productOrderCtrl.translations['antibody.pdp.commerceCard.promotion.promotions']}}
{{$productOrderCtrl.translations['antibody.pdp.commerceCard.promotion.viewpromo']}}
{{$productOrderCtrl.translations['antibody.pdp.commerceCard.promotion.promocode']}}: {{promo.promoCode}} {{promo.promoTitle}} {{promo.promoDescription}}. {{$productOrderCtrl.translations['antibody.pdp.commerceCard.promotion.learnmore']}}
图: 1 / 4
S100A9 Antibody (PA5-85587) in ICC/IF

产品信息
PA5-85587
种属反应
宿主/亚型
分类
类型
抗原
偶联物
形式
浓度
规格
纯化类型
保存液
内含物
保存条件
运输条件
RRID
产品详细信息
Keep as concentrated solution.
Positive Control: MCF-7, MDA-MB-231.
Store product as a concentrated solution. Centrifuge briefly prior to opening the vial.
靶标信息
S100A9 (MRP-14) is a member of the S100 family of proteins containing 2 EF-hand calcium-binding motifs. S100 proteins are localized in the cytoplasm and/or nucleus of a wide range of cells, and involved in the regulation of a number of cellular processes such as cell cycle progression and differentiation. S100 genes include at least 13 members which are located as a cluster on chromosome 1q21. This protein may function in the inhibition of casein kinase and altered expression of this protein is associated with the disease cystic fibrosis.
仅用于科研。不用于诊断过程。未经明确授权不得转售。
篇参考文献 (0)
生物信息学
蛋白别名: BM-009; calgranulin B; Calgranulin-B; Calprotectin L1H subunit; DKFZp686B04128; Leukocyte L1 complex heavy chain; Macrophage; Migration inhibitory factor-related protein 14; Monocyte; MRP-14; MRP15; MRP16; Protein S100-A9; S100 A9; S100 calcium-binding protein A9; S100A9; unnamed protein product
基因别名: 60B8AG; CAGB; CFAG; CGLB; L1AG; LIAG; MAC387; MIF; MRP14; NIF; P14; S100-A9; S100A9
UniProt ID: (Human) P06702
Entrez Gene ID: (Human) 6280




